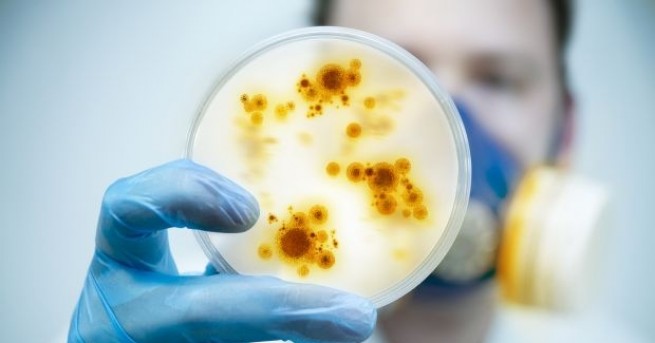
Прицелването в специфична Ахилесова пета на бактериите може да се

... и Positron Annihilation into Dark Matter Experiment в Италия. През идните няколко години трябва да знаем със сигурност дали X17 съществува или не. Източник: New Scientist
Откриха Пета - Новини
Откриха още две жертви на запалилия се ферибот Юрофери Олимпия Очаква
...... роднините не може да го идентифицира. Затова властите предполагат, че е на турския шофьор или на нелегален емигрант.Продължава издирването и агонията на близките на изчезналите.
Открита е пета жертва след пожара на ферибота в Йонийско
...... роднините не може да го идентифицира. Затова властите предполагат, че е на турския шофьор или на нелегален емигрант.Продължава издирването и агонията на близките на изчезналите.
Открита е пета жертва след пожара на ферибота в Йонийско
...... роднините не може да го идентифицира. Затова властите предполагат, че е на турския шофьор или на нелегален емигрант. Продължава издирването и агонията на близките на изчезналите.
Учени от Франкфуртския университет Йохан Волфганг Гьоте определиха 15 кратки
...... дългата молекула РНК може да спре или да забави релпикацията на вируса, защото определени области на генома SARS-CoV-2 могат да бъдат мишена за нови препарати.
Израелски учени направиха пробив в борбата с рака и откриха
...... по-ефективни лечения на рак в бъдеще, тъй като лекарите ще могат да правят тестове за анеуплоидия и в съответствие с това да разработят необходимото лечение.
Израелски учени направиха пробив в борбата с рака и откриха
...... по-ефективни лечения на рак в бъдеще, тъй като лекарите ще могат да правят тестове за анеуплоидия и в съответствие с това да разработят необходимото лечение.
Директорът на Института по биохимия във Франкфурт хърватският
...... и да ни трябва дълго време, за бъдещето това ще бъде голямо откритие. Не само за този вирус, но и за други вируси“, подчерта Дикич.
В хода на специални изследвания учените откриха слабо място в
...... откриха "слабо място" в обвивката на вируса на патогена COVID-19. Резултатите от научната работа на специалисти от английския университет в Саутхемптън бяха публикувани от phys.org.
Полицията в Кипър откри тяло в езеро днес което се
...... за изчезнали жени. Кипърският президент Никос Анастасиадис уволни в петък началника на полицията, а ден по-рано министърът на правосъдието подаде оставка.По публикацията работи: Василия Пейчева
Полицията в Кипър откри тяло в езеро днес което се
...... същото място, където тяло на жена беше намерено в потънал куфар преди седмица. Виж още Серийният убиец в Кипър снимал как изнасилва още една жена
Прицелването в специфична Ахилесова пета на бактериите може да се
...... установили, че комбинация от два ензимни инхибитора и антибиотик от групата на бета-лактамите, е в състояние да унищожи някои от най-устойчивите на антибиотици бактерии.